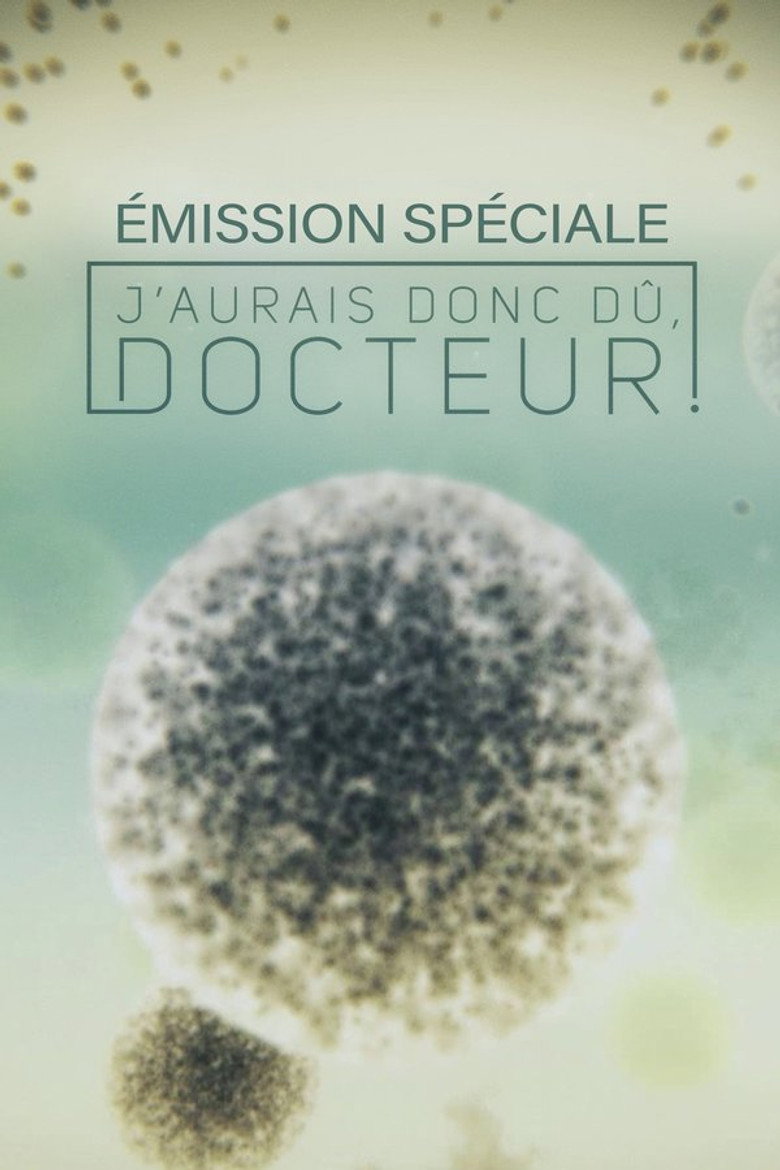

J'aurais donc dû, docteur!
2015
J'aurais donc dû, docteur!
2015

Мы используем систему из 8 критериев для максимальной объективности. Оцените каждый аспект от 1 до 10. Итоговый рейтинг будет рассчитан автоматически.
Выставьте оценки по шкале от 1 до 10 для каждого критерия
Интрига, логика, диалоги
Глубина, развитие, мотивация
Эмоции, харизма, каст
Развязка, послевкусие
CGI, костюмы, оператор
Саундтрек, эффекты
Погружение, стиль, вайб
Свежесть идей, отсутствие клише